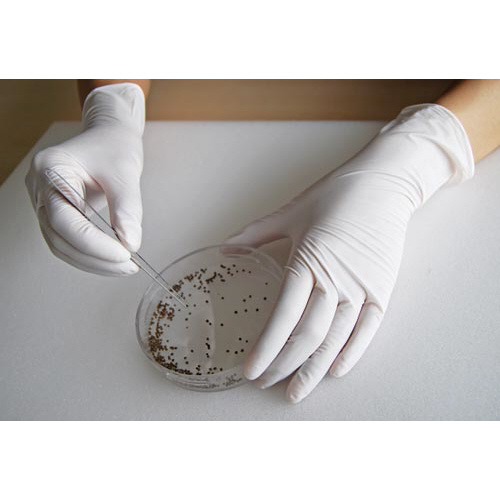

商品情報
商品データ
| 品番コード | 42845652 |
|---|---|
| メーカー名 | ショーワグローブ株式会社 |
| 商品名 | ニトリスト・ホワイト100枚入 ホワイト S 1箱 |
| 商品型番 | NO884-S |
| JANコード | 4901792022873 |
この商品を見た人はこんな商品も見ています
最近チェックした商品
¥355(税抜)
- 最小販売単位
- 1
¥355(税抜)
¥1,180(税抜)
- 最小販売単位
- 1
¥1,180(税抜)
¥136,501(税抜)
- 最小販売単位
- 1
¥136,501(税抜)
¥52,695(税抜)
- 最小販売単位
- 1
¥52,695(税抜)
¥189(税抜)
- 最小販売単位
- 1
¥189(税抜)
¥22,523(税抜)
- 最小販売単位
- 1
¥22,523(税抜)
最近見た商品がありません。

商品説明
※【返品に関するご注意】開封後はお客様のご都合による返品はお受けできません。※アレルギー反応等により、体質によっては、かゆみ・かぶれ発疹等をおこすことがあります。※異常を感じたら使用を中止し、医師に相談して下さい。※高濃度の薬品や溶剤(ガソリン・ベンジン類)には、使用しないで下さい。※膨潤、浸透することがあります。※熱いものに触れないで下さい。※火傷するおそれがあります。※爪先・刃物や尖ったもの等で傷をつけないようご注意下さい。※水がしみこむ原因となります。※感電のおそれがあるため、電気作業には使用しないで下さい。※保管する時には直射日光を避けて下さい。※本品は使いきりのため、再使用しないで下さい。